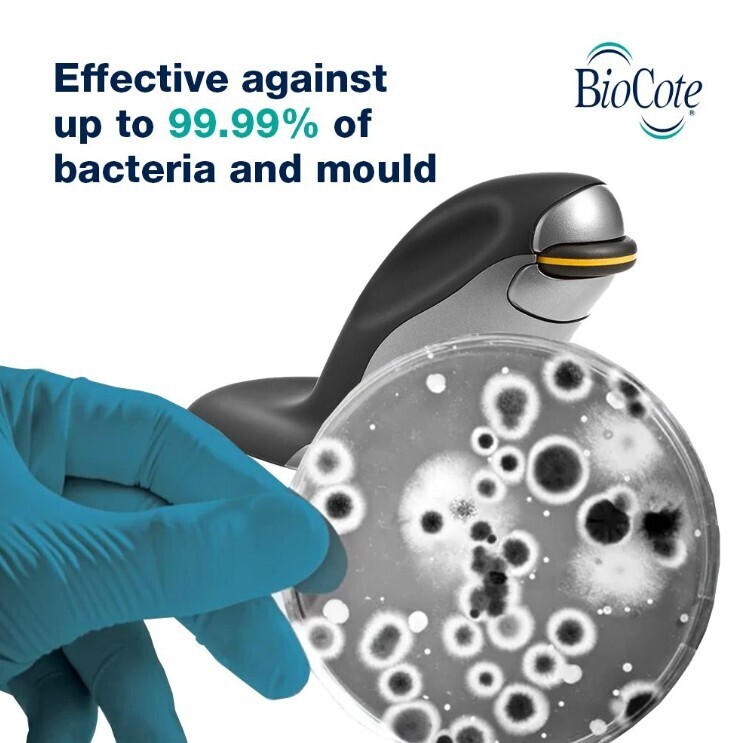

- Aksessuaarid
- Arvutid
- Audio ja hifi
- Diktofoonid
- Kinnitused ja jalused
- Kõlarid
- Kõrvaklapid
- Korvasankakuulokkeet
- Nappikuulokkeet
- Niskasankakuulokkeet
- Oheislaitteet ja tarvikkeet
- Äänirasiat ja neulat
- Antennit
- Basson kielet
- Bluetooth
- Hihnat
- Jalustat ja telineet
- Kitaran kielet
- Kostuttimet
- Kuulokejohdot
- Laajennukset
- Langattomat äänilinkit
- Laukut ja suojat
- Lisäkuulokkeet
- MM-äänirasiat
- Pedaalit
- Plektrat
- Räkkitarvikkeet
- Ristikytkennät
- Rumpukalvot
- Rumpukapulat
- Rumpupenkit
- Rumputelineet
- Säätimet
- Suojaverkot
- Tuulisuojat ja Pop-filtterit
- Tyynyt ja pehmusteet
- Vaihtoneulat
- Varaosat
- Vinyylisoitintarvikkeet
- Virittimet
- Pelikuulokkeet
- Sankakuulokkeet
- Muusikariistad
- Väike hifi
- Võimendid
- Kaablid
- Arvutikomponentide kaablid
- Audiokaablid
- Kaablitarbed
- Lisaseadmete kaablid
- Toitekaablid
- USB-jaoturid
- Videokaablid
- Võrgukaablid
- Kaamerad
- Action-kaamerad
- Autokaamerad
- Binokklid ja teleskoobid
- Digikaamerad
- Digivideokaamerad
- Droonid
- Filtrid
- Kamerakotid
- Kiirkaamerad
- Mälukaardid
- Objektiivid
- Statiivid
- Ammattikäyttöön
- Erikoisjalustat
- Kamerapäät
- Monopodit
- Pöytäjalustat
- Selfietikut
- Tarvikkeet
- Digiscoping
- DJI
- Dollyt
- Etsimet
- Gimbalit
- GoPro
- Harmaakortit
- Hoitotarvikkeet
- Imukuppikiinnikkeet
- Insta360
- Kahvat
- Kalibrointi
- Kauko-ohjaimet
- Kiinnikkeet
- Langaton kuvansiirto
- Lasten aurinkolasit
- Laukut
- LCD-suojat
- Linssisuojat
- Lisäkkeet
- Lisäkkeet/Sovitteet
- Lisenssit
- Mekaaniset kytkimet
- Okulaarit
- Peseytyminen
- Pikakiinnityslevyt
- Projektorien kiinnikkeet
- Projektorihissit
- Pystykahvat
- Runkotulpat
- Sovitteet
- Suojukset
- Tankokiinnikkeet
- Tukivyöt
- Turvaportit ja tarvikkeet
- Tutit ja tuttinauhat
- Varret
- Vastavalosuojat
- Videokuvaus
- WC-tarvikkeet
- Wi-Fi
- Tripodit
- Vakaimet ja gimbalit
- Valaisinjalustat
- Süsteemkaamerad
- Valgustus
- Kellad
- Aktiivsuskäepaelad
- Kellatarbed
- Lasikalvot
- Lataus
- Muut lisätarvikkeet
- Rannekkeet
- Apple Watch -kelloihin
- Apple Watch 42 / 41 / 40 mm -kelloihin
- Apple Watch 46 / 45 / 44 mm -kelloihin
- Apple Watch 49 mm -kelloihin
- Garmin Fenix 5 / 6 / 7 -kelloihin
- Garmin Fenix 5S / 6S / 7S -kelloihin
- Garmin Fenix 5X / 6X / 7X -kelloihin
- Garmin Vivomove / Vivoactive -kelloihin
- Suunto 7 / 9 sekä Spartan Sport-kelloihin
- Lastekellad
- Nutikellad
- Nutisõrmused
- Pulsimõõtjad
- Spordikellad
- Kodu ja valgustus
- Aed ja õu
- Elektroonika ja autondus
- Kodu ja sisustus
- Turvalisus ja automaatika
- Valgustid
- Kodumasinad
- Ahjud
- Kodumasinate tarvikud
- Kuivatid
- Kuivatuskapid
- Külmaseadmed
- Manglid
- Mikrolaineahjud
- Nõudepesumasinad
- Õhupuhastid
- Pesumasinad
- Pesutornid
- Pliidid
- Pliidiplaadid
- Komponendid
- Emaplaadid
- Graafikakaardid
- AMD Radeon RX 7600
- AMD Radeon RX 7700
- AMD Radeon RX 9060 XT
- AMD Radeon RX 9070
- AMD Radeon RX 9070 XT
- Intel ARC
- NVIDIA GeForce GT1030
- NVIDIA GeForce GT730
- NVIDIA GeForce RTX 3050
- NVIDIA GeForce RTX 3060
- NVIDIA GeForce RTX 5050
- NVIDIA GeForce RTX 5060
- NVIDIA GeForce RTX 5060 Ti
- NVIDIA GeForce RTX 5070
- NVIDIA GeForce RTX 5070 Ti
- NVIDIA GeForce RTX 5080
- NVIDIA GeForce RTX 5090
- NVIDIA Quadro
- Helikaardid
- Kontrollerkaardid
- Kõvakettad
- Mälud
- Mikrokontrollerid
- Paigaldus ja jahutus
- Protsessorid
- Kontoritarbed
- Ergonoomika
- Hiiremattid ja randmetoed
- Kalkulaatorid
- Kirjutus- ja esitlustahvlid
- Klammerdurid ja augurauad
- Lamineerimine
- Muud
- Patareid, akud ja laadijad
- Pliiatsid ja pliiatsitarbed
- Prinditarvikud
- Printerid
- Privaatsusfiltrid
- Puhastus
- Purustajad ja lõikurid
- Skannerid
- Vöötkoodilugejad
- Kotid ja reisimine
- Lastetarbed
- Beebimänguasjad
- Elektroonika
- Imetamine ja toitmine
- Jooksurattad ja tõukerattad
- Kandekotid ja kandelinad
- Lapsevankrid ja kärud
- Mööbel ja sisustus
- Turvatoolid
- Lisaseadmed
- Mängimine
- Kinkekaardid
- Lisatooted
- Mängud
- Mängukonsoolid
- Mängumööbel
- Mängupuldid ja -tarvikud
- Nintendo Switch -peliohjaimet
- Nintendo Switch -tarvikkeet
- Nintendo Switch 2 -peliohjaimet
- Nintendo Switch 2 -tarvikkeet
- PC-peliohjaimet
- PlayStation 3 -peliohjaimet
- PlayStation 4 -peliohjaimet
- PlayStation 5 -peliohjaimet
- PlayStation 5 -tarvikkeet
- Retropeliohjaimet
- Tarvikkeet ja lisävarusteet
- Xbox Series S/X -peliohjaimet
- Xbox Series S/X -tarvikkeet
- Retromängimine
- Virtuaalreaalsus
- Mänguasjad
- Basseinid ja ujumismänguasjad
- Figuurid ja mängukomplektid
- Kaugjuhitavad
- LEGO
- DUPLO Classic
- DUPLO Disney
- DUPLO My First
- DUPLO Peppa Pig
- DUPLO Town
- LEGO Animal Crossing
- LEGO Architecture
- LEGO Art
- LEGO Bluey
- LEGO Botanicals
- LEGO City
- LEGO Classic
- LEGO Creator
- LEGO Disney Classic
- LEGO Disney Princess
- LEGO DREAMZzz
- LEGO Editions
- LEGO Fortnite
- LEGO Friends
- LEGO Gabbyn Nukketalo
- LEGO Harry Potter
- LEGO Horizon Adventures
- LEGO Icons
- LEGO Ideas
- LEGO Jurassic World
- LEGO Minecraft
- LEGO Ninjago
- LEGO ONE PIECE
- LEGO Pixar
- LEGO Pokemon
- LEGO Sonic the Hedgehog
- LEGO Speed Champions
- LEGO Star Wars
- LEGO Super Heroes
- LEGO Super Mario
- LEGO Technic
- LEGO Wednesday
- LEGO Wicked
- LEGO-harvinaisuudet
- Loovmäng ja meisterdamine
- Mänguasja advendikalendrid
- Mängud ja õppimine
- Nukud ja pehmed mänguasjad
- Õuemänguasjad
- Sõidukid ja rajad
- Mängukonsoolid
- Mobiiltelefonid
- Muusika
- DJ-seadmed
- Kitarrid
- Klahvpillid
- Klassikalised instrumendid
- Laste muusikariistad
- Muud tooted
- PA- ja esitlustehnika
- Salvestid
- Studioseadmed
- Süntesaatorid
- Tarkvara
- Trummid
- Nutikell
- Nutikodu
- Sport
- Discgolf
- Elektrilised sõidukid
- Fitness
- Golf
- Jalgrattasõit
- Harjoitusvastukset
- Polkupyörän renkaat
- Polkupyörät
- Pyöräilykypärät
- Pyöräilytarvikkeet ja varaosat
- Juomapullotelineet
- Kädensijat ja tankonauhat
- Ketjuöljyt ja puhdistus
- Lastenistuimet pyörään
- Lokasuojat
- Navat ja akselit
- Ohjainkannattimet ja tangot
- Polkupyörän jarrut
- Polkupyörän lukot
- Polkupyörän polkimet
- Polkupyörän pumput
- Polkupyörän satulat ja istuinkannattimet
- Polkupyörän työkalut
- Polkupyörän vanteet
- Polkupyörän varaosat
- Pyöräilyelektroniikka
- Pyöräilylasit
- Pyöräilyreput
- Pyöräkärryt
- Pyöränkuljetuslaukut
- Pyöränkuljetustelineet
- Seisontatuet
- Soittokellot ja peilit
- Suojavarusteet
- Tavarankuljetus
- Voimansiirto
- Sähköpyörät
- Korvpall
- Lihashooldus
- Matkamine ja matkavarustus
- Padel
- Spordivalgustid
- Sulgpall
- Talvesport
- Tennis
- Tahvelarvuti
- Telefonid
- Android-telefonid
- Apple iPhone
- Kaitsekiled
- Kasutatud telefonid
- Laua-GSM
- Merenduse elektroonika
- Muud tarvikud
- Navigeerimine
- PL-telefonid
- Põhitelefonid
- Raadiosaatjad
- Telefonihoidjad
- Telefonilaadijad
- Ümbrised ja kaitsekestad
- Suojakotelot / Apple iPhone
- iPhone 11
- iPhone 11 Pro
- iPhone 11 Pro Max
- iPhone 12
- iPhone 12 mini
- iPhone 12 Pro
- iPhone 13 mini
- iPhone 13 Pro
- iPhone 14
- iPhone 14 Plus
- iPhone 15
- iPhone 15 Plus
- iPhone 15 Pro
- iPhone 15 Pro Max
- iPhone 16
- iPhone 16 Plus
- iPhone 16 Pro
- iPhone 16 Pro Max
- iPhone 5
- iPhone 6 / 6s
- iPhone 7
- iPhone 7 Plus
- iPhone 8
- iPhone SE
- iPhone SE 2022 / 2020
- iPhone X
- iPhone XR
- Suojakotelot / Doro
- Suojakotelot / Fairphone
- Suojakotelot / Google Pixel
- Suojakotelot / HMD
- Suojakotelot / Honor
- Honor 20 -sarja
- Honor 200
- Honor 200 Lite
- Honor 200 Pro
- Honor 200 Smart
- Honor 400
- Honor 400 Lite
- Honor 400 Pro
- Honor 400 Smart
- Honor 50
- Honor 7 -sarja
- Honor 70
- Honor 8
- Honor 90
- Honor 90 Lite
- Honor 9X Lite
- Honor Magic 8 Lite
- Honor Magic 8 Pro
- Honor Magic5 Lite
- Honor Magic6 Lite
- Honor Magic6 Pro
- Honor Magic7 Lite
- Honor Magic7 Pro
- Honor X5c Plus
- Honor X6a
- Honor X6b
- Honor X7
- Honor X7a
- Honor X7b
- Honor X8
- Suojakotelot / Motorola
- Suojakotelot / Nokia
- Suojakotelot / Nothing Phone
- Suojakotelot / OnePlus
- OnePlus 10 Pro
- OnePlus 10 T
- OnePlus 11
- OnePlus 12
- OnePlus 12R
- OnePlus 13
- OnePlus 15
- OnePlus 15R
- OnePlus 8
- OnePlus 8T
- OnePlus 9
- OnePlus 9 Pro
- OnePlus Nord
- OnePlus Nord 2 5G
- OnePlus Nord 2T 5G
- OnePlus Nord 3 5G
- OnePlus Nord 4 5G
- OnePlus Nord 5 5 G
- OnePlus Nord CE
- OnePlus Nord CE 2
- OnePlus Nord CE 2 Lite
- OnePlus Nord CE 3 Lite 5G
- OnePlus Nord CE4 Lite
- OnePlus Nord CE5 5G
- OnePlus Nord N100
- Suojakotelot / OPPO
- Suojakotelot / Rugged phones
- Suojakotelot / Samsung
- Galaxy A02s
- Galaxy A03
- Galaxy A05s
- Galaxy A10
- Galaxy A12
- Galaxy A13
- Galaxy A14
- Galaxy A14 5G
- Galaxy A15
- Galaxy A16
- Galaxy A17 5G
- Galaxy A20e
- Galaxy A21s
- Galaxy A22 5G
- Galaxy A23 5G
- Galaxy A25
- Galaxy A26
- Galaxy A32 5G
- Galaxy A33 5G
- Galaxy A34
- Galaxy A35
- Galaxy A36
- Galaxy A40
- Galaxy A41
- Galaxy A42 5G
- Galaxy A5 (2017)
- Galaxy A51
- Galaxy A51 5G
- Galaxy A52
- Galaxy A53 5G
- Galaxy A54
- Galaxy A55
- Galaxy A56
- Galaxy A7 (2018)
- Galaxy A70
- Galaxy A71
- Galaxy A8 (2018)
- Galaxy A80
- Galaxy J5 (2016)
- Galaxy J5 (2017)
- Galaxy S10 Lite
- Galaxy S10+
- Galaxy S20
- Galaxy S20 FE
- Galaxy S20 Ultra
- Galaxy S21
- Galaxy S21 FE
- Galaxy S22
- Galaxy S22 Ultra
- Galaxy S23
- Galaxy S23 FE
- Galaxy S23 Ultra
- Galaxy S24
- Galaxy S24 FE
- Galaxy S24 Ultra
- Galaxy S25 Edge
- Galaxy S25 FE
- Galaxy S25 Ultra
- Galaxy S25+
- Galaxy S26
- Galaxy S26 Ultra
- Galaxy S8
- Galaxy S9
- Galaxy XCover -sarja
- Galaxy Z Flip
- Galaxy Z Flip7
- Galaxy Z Fold
- Galaxy Z Fold7
- Suojakotelot / Sony
- Suojakotelot / Xiaomi
- Urheilukotelot
- Vaakalaukut
- Yleiset suojapussit ja tarvikkeet
- Suojakotelot / Apple iPhone
- Vabakäeseadmed
- Toit ja jook
- TV ja video
- Väikeseadmed
- Aknapesurid
- Aurupesijad
- Elektrilised hambaharjad ja otsikud
- Grillimine
- Ilu ja tervis
- Juuksehooldus
- Karboniseerimisseadmed
- Kliima ja õhk
- Kohv
- Köögiseadmed
- Airfryerit
- Friteerauskeittimet
- Haudutuspadat
- Höyrykeittimet
- Jääpalakoneet
- Jäätelökoneet
- Kasvikuivurit
- Keittiövaa'at
- Keittolevyt ja miniuunit
- Leivänpaahtimet
- Lihamyllyt
- Mehulingot ja mehupuristimet
- Monitoimikoneet
- Munankeittimet
- Popcorn-koneet
- Pöytägrillit
- Riisinkeittimet
- Sähkövatkaimet
- Sauvasekoittimet
- Teholeikkurit ja viipalointikoneet
- Tehosekoittimet
- Vakuumikoneet
- Vedenkeittimet
- Vohveliraudat
- Yleiskoneet
- Köögitarbed
- Õmblusmasinad
- Pardlid ja trimmerid
- Tolmuimejad
- Triikrauad ja rõivaaurutid
- Võrk